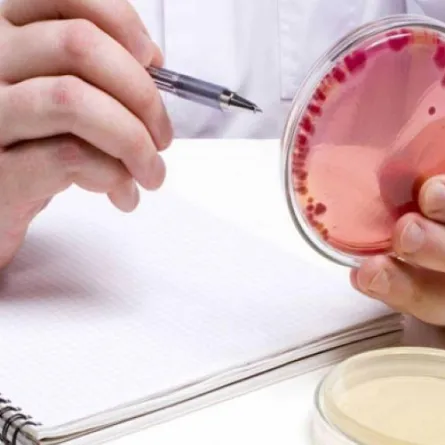
باحثون أمريكيون يبتكرن تقنية لتجديد جلد الإنسان

مع التقدم الرقمي المتسارع في العالم توقع مدير المنتجات الرقمية في شركة "Veon" "جورج هيلد" أنه سيتم التخلص التدريجي من الهواتف الذكية في غضون عشر سنوات.
وسيصبح الهاتف الذكي بدائيًا، وسيتم استبداله بتقنيات أكثر تقدمًا في الأعوام القليلة القادمة.
وأشار إلى أن الجهاز المحمول مطلوب حاليًا فقط لمصادقة المستخدم ونقل المعلومات.
وأوضح أنه يمكن التعرف على الشخص بشكل مختلف على سبيل المثال من خلال الوجه أو بصمات الأصابع والصوت، ويمكن عرض المعلومات على الحائط أو المرآة باستخدام مستشعر إنترنت الأشياء "IoT" أو "Internet of Things".
وأضاف: "لذلك فإنه في غضون 10 سنوات سوف يختفي، وسنحل محله نحن الناس. والجدة التي فقدت في وسط المدينة لن تحتاج إلى الاتصال بأي مكان يمكنها أن تسأل الجدار "كيف يمكنني العودة إلى المنزل؟" وسيوضح لها الجدار الطريق بسهم
وخلص إلى أن الهاتف الذكي مثل الشريحة المزروعة، هو تقنية عفا عليها الزمن، لذا في غضون عشر سنوات ستصبح نادرة.
وفي وقت سابق ابتكر علماء أمريكيون جهازًا يسمح لك بتوليد الطاقة من أصابع الإنسان. وهو عبارة عن شريط رفيع متصل بنهايات عصبية. ويتم توليد كمية أكبر من الكهرباء فيه عندما يتولد العرق.



 Google News
Google News